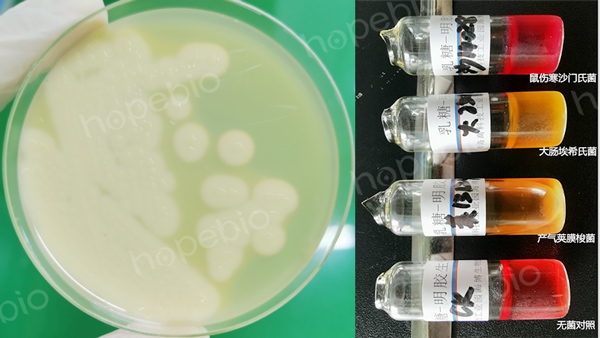
新旧版本标准中可疑菌的确证方法试验结果比较

海博微信公众号
海博微信公众号
 海博天猫旗舰店
海博天猫旗舰店


 海博微信公众号
海博微信公众号
 海博天猫旗舰店
海博天猫旗舰店




一、标准简介
在饮用天然矿泉水检验方法(GB 8538)中,产气荚膜梭菌的检验一直是一个必检项目。新版《GB 8538-2022 食品安全国家标准 饮用天然矿泉水检验方法》已于2022.6.30发布,2022.12.30正式实施。与旧版本相比,新版标准中,在产气荚膜梭菌检验方法上对计数培养基、分离方法、确证试验和计数方法方面都有较大的变动,本文主要对这些改动进行逐一说明。
二、培养基的改变
旧版标准《GB 8538-2016 食品安全国家标准 饮用天然矿泉水检验方法》中规定分离培养基采用SPS(亚硫酸盐-多粘菌素-磺胺嘧啶琼脂),但新标准中明确改用TSC(胰䏡-亚硫酸盐-环丝氨酸琼脂)对样品中的产气荚膜梭菌进行分离培养。
有关这两种培养基的异同及产气荚膜梭菌在这两种培养基上的菌落形态等,可参考文章:两种产气荚膜梭菌检验培养基的对比 点击查看
三、分离方法的改变
新旧版本对样品中产气荚膜梭菌的检验都涉及滤膜过滤法,但新版标准中,对于滤膜的孔径描述更加规范(0.45μm)。
对于带菌滤膜的使用,旧版标准中是直接“将滤膜移至SPS琼脂培养上”,倒置培养;而新版标准中,除了按照旧版标准的方法将滤膜转移到TSC培养基上外,还要求“倾注5mL~10mL冷却至50℃的TSC琼脂均匀覆盖滤膜表面”,在分离方法的操作上相对旧版有所改变。
两种分离试验方法所取得的试验结果如图1所示:

图1 产气荚膜梭菌分离试验结果(左:旧版方法; 右:新版方法)
四、确证试验方法的改变
旧版标准中,对可疑菌的确证试验方法为:镜检形态、动力、硝酸盐还原、牛奶发酵、卵磷脂分解;而新版标准中,则采用镜检、动力-硝酸盐试验、牛奶发酵试验和乳糖-明胶试验的方法,差异部分的试验结果如图2。
有关这些验证试验的结果现象等详细信息,可参考文章:产气荚膜梭菌检验解析及注意事项 点击查看
图2 新旧版本标准中可疑菌的确证方法试验结果比较
(左:旧标准 卵磷脂分解试验; 右:新标准 乳糖-明胶试验)
五、计数方法的改变
旧版标准中规定“挑取可疑黑色菌落3个-5个”,进行后续培养确证;新版标准则要求“按比例挑取10个不同形态的可疑菌落(不足10个则全挑)”进行后续培养确证试验。在挑取的菌数和挑菌方法上都做了更加严格明确的规定。并且,新版标准还明确给出了菌数计算公式和报告方式(如图3)。

图3 新版标准中有关结果与报告的规定
六、讨论
新版标准除了在培养基、分离方法、确证方法和计数方法方面有所改变外,在语言描述方面也更加严谨规范。修订后的版本,更贴近于食品中产气荚膜梭菌检验(如图4)。

图4 不同的食品安全国家标准中对产气荚膜梭菌的检验程序
(左:GB 4789.13-2012 右:GB 8538-2022)
相关标准:
GB 8538-2022 食品安全国家标准 饮用天然矿泉水检验方法 -点击标准下载
注:本文属海博生物原创,未经允许不得转载。
上一篇:阴沟肠杆菌的检验方法及结果判断
| 相关文章: | ||



